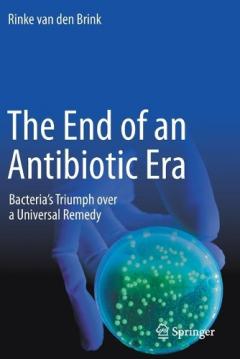
END OF AN ANTIBIOTIC ERA

END OF AN ANTIBIOTIC ERA
Categories:
Language:
Engleza
Publishing Date:
2021
Publisher:
Cover Type:
Paperback
ISBN:
9783030707224
23200
Supplier stock
Delivery in 2 to 3 weeks!
Price applicable only to online purchases!
Free Gift Wrapping!
Free shipping over 150 RON
You can return it in 14 days
You got questions? Contact Us!